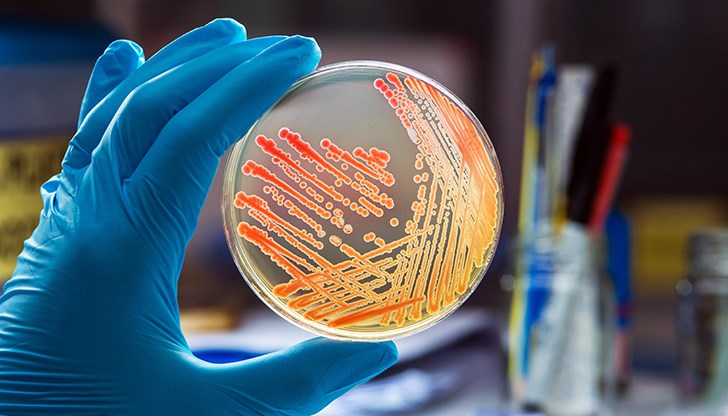
Той се е заразил след като се е измил с чешмяна вода Той се е заразил след като се е измил с чешмяна вода

Мъж почина след заразяване с амеба, разяждаща мозъка, в САЩ
- Редактор: Мартин Руменов
- Коментари: 4
Той се е заразил след като се е измил с чешмяна вода
Мъж в Флорида почина след заразяване с амеба, разяждаща мозъка, съобщава Ен Би Си Нюз, предаде bTV.
Според властите човек може да се зарази, когато вода е замърсена с амеба и влезе през носа
Мъжът е починал на 20 февруари, което е три дни преди здравните власти в окръга да издадат сигнал за инфекцията.
Според властите инфекцията е рядка и човек може да се зарази, когато вода е замърсена с амеба и влезе през носа.
Амебата може да причини инфекция на мозъка, известна като първичен амебичен менингоенцефалит – състояние, за което няма известни ефективни лечения. Тя обикновено живее в топли, сладководни езера, реки и горещи извори.



















